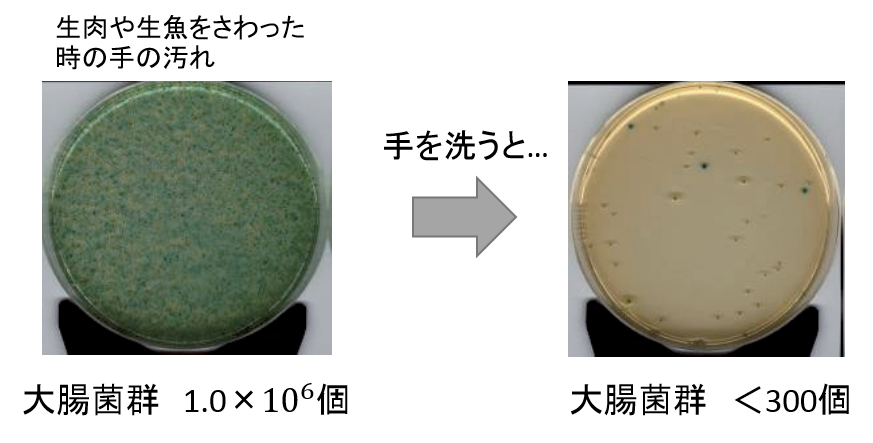
手を洗うと、手についた細菌やウイルスをおとすことができます

どうして手を洗うの?
実は、人の手には目に見えない細菌やウイルスがついています。
これらは、食中毒の原因となってしまいます。
![]() |
| 細菌やウイルスがついた手で 食材を触ると・・・ |
食材に細菌やウイルスが ついてしまいます。 |
つくった食べ物にも細菌やウイルスがついています。 |
手を洗うと、手についた細菌やウイルスをおとすことができます。
| ※大腸菌群とは、人や動物の糞便や、工場、水、空気中などに分布しており、 これら環境からの汚染を調べるときに使われます。 |


→トップページへ
お問合せ先
消費・安全局食品安全政策課
担当者:情報発信企画・評価班
代表:03-3502-8111(内線4474)
ダイヤルイン:03-6744-2135





